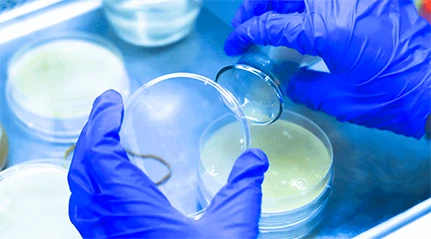
page-1-1

HSF молекулна лаборатория (Добре дошли да си уговорите среща за посещение →)

Изграждане на микроорганизми на HSF биотехнологична ферментация
Изследователите от лабораторията на HSF Molecule провеждат многобройни анализи на транскриптоми и протеомика на микробните щамове, установяват множество
Независими библиотеки на деформация и извършване на насочено опитомяване на щамове чрез процеси като UV облъчване и плазмено лечение.



HSF Biotech Company се фокусира тясно върху ферментацията и техниките на молекулярна биология за изследване на структурата и функцията на биомакромолекулите (протеини и нуклеинови киселини) на молекулно ниво. Те извършват скрининг с висока пропускателна способност, използват молекулярно докинг за идентифициране на ключови функционални домейни на протеини, оптимизират критичните остатъци в домейните за свързване на субстрата и анализират микробния растеж и ключовите ензимни свойства, използвайки модерни техники за синтетична биология.

Те непрекъснато оптимизират условията на ферментация като температура, кислород, рН, както и добавяне на субстрат и хранителни вещества, като се използват международно напреднало напълно автоматизирано оборудване за ферментация, за да контролират прецизно микробния растеж и условията на трансформация, което води до високодоходни ферментационни продукти.


HSF разполага с пълни платформи за добив и оптимизация на микробните щам, микробна прецизност, напълно контролирана, както и напреднало развитие на ензима на зелен ензим. By using molecular biology and microbial strain optimization technology as to conduct in-depth analysis and change the metabolic pathway of industrial microorganisms to obtain directional high-yield strains, HSF utilizes modern biological bacteria fermentation engineering technology to prepare functional factors, further explore and extract natural functional ingredients, which is applied to functional food processing, and improve the added value of products, expand the breadth and depth of product приложение.



